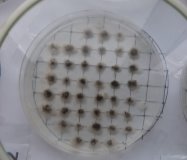
C:\Users\Светлана Михайловна\AppData\Local\Microsoft\Windows\INetCache\Content.Word\IMG-20191024-WA0005.jpg
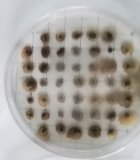
C:\Users\Светлана Михайловна\AppData\Local\Microsoft\Windows\INetCache\Content.Word\IMG_20191028_100710.jpg

Почва служит основным средством сельскохозяйственного производства, экономической основой существования людей, но не стоит забывать, что здоровье человека зависит от качества растительной продукции [1].
По данным Роспотребнадзора, современные удобрения, используемые для выращивания сельскохозяйственных растений, содержат чрезмерное количество химикатов, они способны преобразовывать биохимический состав растительных продуктов питания: количество витаминов и микроэлементов в них резко сокращается и, если химикатов слишком много, все полезные вещества могут полностью заменяться нитратами. При регулярном употреблении таких продуктов, вместо ожидаемой пользы, человек получает головную боль, головокружение, сбои в работе сердца, тахикардию, онемение мышц, нарушение слуха и зрения [2].
Несмотря на это, нитраты необходимы растениям, как источник азота для роста и развития. Азот из воздуха растения усваивать не могут. Этот процесс проводится только бактериями. Перевод элементов питания в доступную для растений форму, в частности азота — одна из важных функций бактерий р. Azotobacter. Биологический азот является наиболее безопасным для человека, так как не происходит накопления нитратов. Кроме того, данные бактерии, развиваясь около корней растений, стимулируют их рост [1].
Цель работы: изучение штаммов бактерий р. Azotobacter в условиях открытого и закрытого грунта.
Задачи:
- Узнать особенности почвы, из которой были извлечены бактерии р. Azotobacter.
- Определить культурально-морфологические свойства штаммов, выделенных из образцов почв и установить зависимость их встречаемости от типа грунта (закрытый/открытый).
- Установить стимулирующую активность выделенных штаммов азотфиксирующих бактерий.
Предмет исследования: штаммы бактерий р. Azotobacter
Объект исследования: почвы открытого и закрытого грунта
Гипотезы: в условиях закрытого грунта встречаемость бактерий р. Azotobacter выше; данные бактерии стимулируют прорастание семян культурных растений.
Первым этапом работы было изучение состояния почв, а именно определение механического состава, рН среды, наличия карбонатов. Отбор проб почвы производился с двух разных огородов и теплиц, находящихся на расстоянии 2600 метров (улицы Южная, Рабочая). Географические координаты: N55E82. Причина выбора этих мест: слабое загрязнение почв (выявлено ранее методом биотестирования при помощи семян кресс-салата), что, возможно, благоприятно скажется на многообразии штаммов азотфиксирующих бактерий. Участки удалены от крупной автомобильной магистрали, поэтому невысока вероятность оседания на почве частиц выхлопных газов автотранспорта. 20.10.2019 г. сделаны поверхностные почвенные разрезы глубиной от 0,40 до 0,50 метра.
Вывод: образцы почв имеют сходные показатели: механический состав — среднесуглинистый, рН среды = 6 (слабокислая), незначительное количество карбонатов.
Второй этап работы — выявление микроорганизмов р. Azotobacter в данных образцах почв. Для этого брали из просеянной и увлажненной почвы комочки диаметром 3–4 мм. и помещали в чашки Петри на питательную среду Эшби [3].

Рис. 1. Чашки Петри с посевами
Наблюдение и микроскопический анализ полученных колоний микроорганизмов показал, что во всех образцах почв присутствуют клетки бактерий рода Azotobacter.
|
|
|
Рис. 2. Вид обрастаний
Вывод. Выявлена следующая закономерность: в условиях закрытого грунта из проб почвы, взятой на глубине 20 см., процент обрастания составил 100 % и 94 %/ 95 % (Улица Южная/Улица Рабочая) — на поверхности. В условиях открытого грунта: на глубине 20 см. — 98 %/94 %, на поверхности — 99 %/96 %. Мы предполагаем, что в условиях закрытого грунта поверхность почвы быстро теряет влагу и отсутствует её естественный источник, следовательно, бактерии сосредоточены в более глубоких влажных слоях (кроме того, почва насыпная, она достаточно рыхлая и насыщена кислородом).
Общее количество обрастаний на четвертый день составило 100 % во всех пробах почвы. При этом часть комочков почвы обросли светлыми колониями, часть — темными.

Рис. 3. Соотношение светлых и темных колоний на четвертый день (Ул. Южная)

Рис. 4. Соотношение светлых и темных колоний на четвертый день (Ул. Рабочая)
Вывод . Соотношение светлых и темных колоний из разных мест отличается как в закрытом, так и открытом грунте:
- Ул. Южная — преобладают темные колонии, что свидетельствует о защитной реакции клеток на воздействие неблагоприятных условий.
- Ул. Рабочая — преобладают светлые колонии с желтой или со светло-коричневой пигментацией.
Все клетки выделенных образцов представляют собой шаровидные формы и имеют образования в виде капсул. Присутствие цист обнаружено не во всех культурах.
|
Рис. 5. Колонии бактерий открытого грунта (1- поверхность, 2 — глубина 20 см.) (Ул. Южная). |
Рис. 6. Колонии бактерий закрытого грунта, глубина 20 см. (1- светлая колония, 2- темная колония) (Ул. Южная). | ||
|
1 |
2 | ||
Рис. 7. Бактерии с поверхности открытого грунта (1- светлая колония) и с глубины 20 см. закрытого грунта, (2- темная колония) (Ул. Рабочая).
На третьем этапе работы изучили стимулирующую активность выделенных штаммов бактерий р. Azotobacter. Для этого выбрали семена красной и белой фасоли, выращенных на собственном огороде. Семена, предназначенные для опытов, одного размера и не подвергались никакой химической обработке. В качестве субстрата на дно чашек Петри положили вату, увлажнённую одним и тем же количеством водопроводной воды с добавлением выделенных штаммов бактерий р. Azotobacter (на 50 мл. воды брали слизистую пленку светло-жёлтых колоний бактерий размером с горошину (независимо от типа грунта (закрытый/открытый)). Сверху семена прикрыли субстратом из ваты, смоченным водопроводной водой. Проращивание происходило в комнатных условиях при температуре 22–25°С. У контрольных образцов субстрат смачивали водопроводной водой.
Для установления стимулирующей активности выделенных штаммов бактерий р. Azotobacter, поставили по три параллельных эксперимента. Через трое суток зафиксировали результаты наблюдений.
Всхожесть красных семян фасоли на субстрате, смоченном водой с добавлением бактерий р. Azotobacter выше контрольных образцов на 9 %, белых семян — на 5 %. Общая длина корней, появившихся из зародышевого корешка красных семян фасоли на субстрате, смоченном водой с добавлением бактерий р. Azotobacter больше длины корней контрольных образцов на 7,2 см., белых семян — на 1,3 см. Кроме того, нами замечено, что семена, пророщенные в присутствии бактерий обладали ростовой силой — крышки чашек Петри были заметно приподняты, корни упирались в субстрат (в контрольных образцах такого явления не наблюдали).
Вывод: бактерии р. Azotobacter стимулируют прорастание семян и ускоряют развитие растений.

12
Рис. 8. Длина корней проросших красных семян фасоли (1 — в присутствии бактерий р. Azotobacter, 2 — в водопроводной воде)
В результате исследования, пришли к следующим выводам:
- Исследуемая почва обладает свойствами, подходящими для обитания бактерий р. Azotobacter.
- Все клетки выделенных образцов представляют собой шаровидные формы и имеют образования в виде капсул. Присутствие цист обнаружено не во всех культурах. Наша гипотеза о зависимости встречаемости бактерий от типа грунта (закрытый/открытый) не подтвердилась.
- Наша гипотеза о стимулирующей активности бактерии р. Azotobacter подтвердилась.
Литература:
- Звягинцев Д. Г., Бабьева И. П., Зенова Г. М. Биология почв: Учебник. — 3-изд., испр. и доп.— М.: Изд-во МГУ, 2005. — 445 с., илл. — (Классический университетский учебник)
- О вреде нитратов. Источник: http://04.rospotrebnadzor.ru/index.php/san-nadzor/43-san-ottel/4739–22052015.html
- Охотник за микробами. Методические рекомендации и инструкции по применению набора.